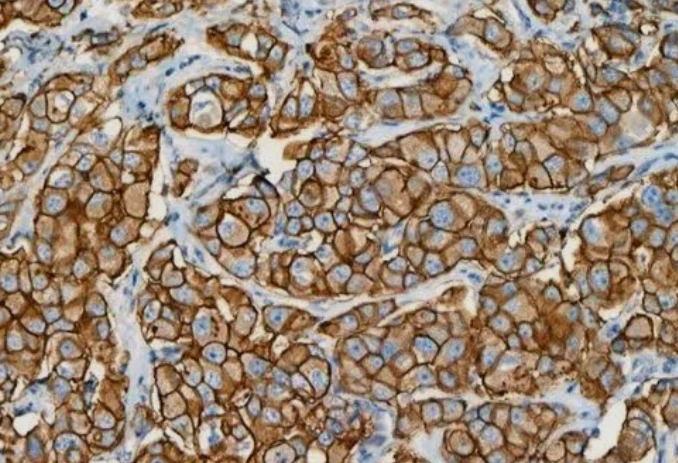
Immunohistochemistry: Her-2

تفاصيل التحليل
فحص مستقبل HER2 الكيميائي النسيجي المناعي (HER2)
فحص حيوي لتحديد العلاج الموجه لسرطان الثدي والمعدة، حيث يكشف عن بروتين HER2 لضمان اختيار العلاج المناعي الأكثر فعالية وتحسين فرص التعافي.
الصورة التوضيحية المرتبطة بهذا التحليل